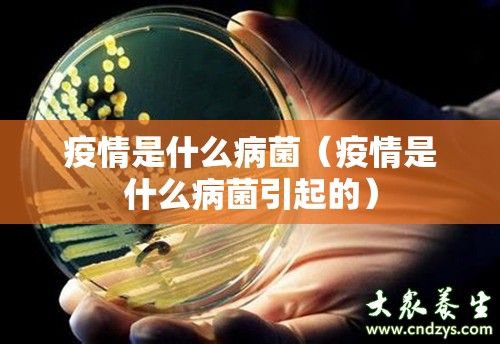
今日重大通报“BB棋牌怎么买挂确实真的有挂”√必胜开挂神器 今日重大通报“BB棋牌怎么买挂确实真的有挂”√必胜开挂神器

今日重大通报“BB棋牌怎么买挂确实真的有挂”√必胜开挂神器
您好:BB棋牌这款游戏是可以开挂的,软件加微信【8984612】确实是有挂的,很多玩家在BB棋牌这款游戏中打牌都会发现很多用户的牌特别好,总是好牌,而且好像能看到其他人的牌一样。所以很多小伙伴就怀疑这款游戏是不是有挂,实际上这款游戏确实是有挂的,添加客服微信【8984612】安装软件.
1.BB棋牌怎么买挂确实真的有挂 这款游戏是可以开挂的,确实是有挂的,通过添加客服微信【8984612】安装这个软件.打开.
2.在"设置DD辅助功能DD微信麻将辅助工具"里.点击"开启".
3.打开工具加微信【8984612】.在"设置DD新消息提醒"里.前两个选项"设置"和"连接软件"均勾选"开启".(好多人就是这一步忘记做了)
亲,这款游戏原来确实可以开挂,详细开挂教程
1、起手看牌
2、随意选牌
3、控制牌型
4、注明,就是全场,公司软件防封号、防检测、 正版软件、非诚勿扰。
2022首推。
全网独家,诚信可靠,无效果全额退款,本司推出的多功能作 弊辅助软件。软件提供了各系列的麻将与棋 牌辅助,有,型等功能。让玩家玩游戏,把把都可赢打牌。
详细了解请添加《》(加我们微)
本司针对手游进行破解,选择我们的四大理由:
1、BB棋牌怎么买挂确实真的有挂软件助手是一款功能更加强大的软件!
2、自动连接,用户只要开启软件,就会全程后台自动连接程序,无需用户时时盯着软件。
3、安全保障,使用这款软件的用户可以非常安心,绝对没有被封的危险存在。
4、打开某一个微信【8984612】组.点击右上角.往下拉."消息免打扰"选项.勾选"关闭"(也就是要把"群消息的提示保持在开启"的状态.这样才能触系统发底层接口)
说明:BB棋牌怎么买挂确实真的有挂 是可以开挂的,确实是有挂的,。但是开挂要下载第三方辅助软件,BB棋牌怎么买挂确实真的有挂 ,名称叫BB棋牌怎么买挂确实真的有挂 。方法如下:BB棋牌怎么买挂确实真的有挂 ,跟对方讲好价格,进行交易,购买第三方开发软件。
【央视新闻客户端

发表评论